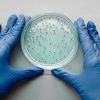
Probiotiques santé bienfaits

- Probiotiques après les fêtes : rééquilibrer vite son microbiote L’expression probiotiques après les fêtes résume parfaitement la période critique où l’organisme cherche à rétablir son …
- Détox post-fêtes : ce que la science dit vraiment La requête cible détox post-fêtes est aujourd’hui l’un des sujets les plus recherchés en nutrition fonctionnelle. Dans ce premier paragraphe, nous …
- Fatigue de janvier : micronutriments essentiels pour retrouver de l’énergie Chaque année, la fatigue de janvier s’impose comme un phénomène quasi universel. Après les fêtes, le changement …
- Le sujet des compléments pour soutenir le foie intéresse de plus en plus de consommateurs en quête de bien-être digestif et métabolique, notamment après des repas riches où les fonctions hépatiques …
- Micronutrition récupération fêtes : comment optimiser votre retour à l’équilibre La micronutrition récupération fêtes est un concept clé pour soutenir l’organisme après une période d’excès …
- Sodium et régime keto : l’électrolyte oublié qui change tout Le sodium et régime keto sont deux notions indissociables lorsqu’on s’intéresse à la physiologie du métabolisme cétogène. Trop souvent …
- Régime keto Wegovy compléments alimentaires : un duo gagnant Le régime keto Wegovy compléments alimentaires constitue aujourd’hui une approche innovante pour la perte de poids durable et …
- Magnésium et Mounjaro : réduire les effets secondaires naturellement Le magnésium et Mounjaro sont aujourd’hui au cœur de nombreuses discussions médicales et scientifiques. Alors que Mounjaro …
- Chrome et Wegovy : l’alliance gagnante pour la gestion du glucose Le duo chrome et Wegovy suscite un intérêt croissant dans le domaine de la santé métabolique et de la perte de poids. Alors …
- Wegovy Mounjaro et autres : quels compléments pour prévenir la perte de masse musculaire ? L’utilisation de traitements comme Wegovy et Mounjaro, puissants agonistes des récepteurs du GLP-1 et GIP, …
- Comment choisir un bon probiotique : guide scientifique pour débutants Choisir un bon probiotique peut sembler complexe, surtout lorsqu’on débute. Pourtant, comprendre les bases scientifiques et …
- Spiruline et chlorella : super-aliments aux bienfaits prouvés La spiruline et la chlorella sont aujourd’hui reconnues comme deux super-aliments majeurs grâce à leur richesse nutritionnelle et leur …
- Sommeil et compléments keto : améliorer la qualité du repos et la perte de poids Le sommeil et les compléments keto sont deux leviers essentiels pour réussir un régime cétogène et maintenir une santé …
- Caféine et régime cétogène : synergie, effets et compléments NUTRILUX Santé Le duo caféine et régime cétogène fascine autant les chercheurs que les passionnés de nutrition. Comprendre comment la …
- Charbon actif cure détox keto : allié puissant avec NUTRILUX Santé Le charbon actif cure détox keto est devenu un incontournable des stratégies nutritionnelles modernes. Utilisé depuis l’Antiquité …
- Adaptogènes et régime keto : alliés scientifiquement validés ? Le sujet des adaptogènes et régime keto suscite un intérêt croissant dans le monde de la nutrition fonctionnelle et de la …
- Mounjaro et probiotiques : une synergie pour le microbiote et la santé intestinale L’association Mounjaro et probiotiques suscite aujourd’hui un intérêt croissant dans la recherche …
- Oméga-3 et régime riche en graisses : l’essentiel pour votre santé Les oméga-3 et régime riche en graisses représentent aujourd’hui une association incontournable dans la nutrition moderne. …
- Chrome et Wegovy : booster la régulation glycémique Le couple Chrome et Wegovy attire de plus en plus l’attention dans le domaine de la nutrition et de la médecine métabolique. Ces deux …
- BCAA en régime keto : préserver la masse musculaire avec NUTRILUX Santé Le régime cétogène, riche en graisses et très pauvre en glucides, entraîne une adaptation métabolique particulière qui peut …
- Microbiote intestinal et régime cétogène : l’alliance santé signée NUTRILUX Santé Le microbiote intestinal et régime cétogène sont deux sujets étroitement liés qui suscitent un grand intérêt …
- Qu’est-ce que Wegovy ? Wegovy est un médicament récent appartenant à la famille des agonistes du GLP-1 (glucagon-like peptide-1). Son principe actif, le sémaglutide, imite une hormone intestinale qui …
- Zinc et régime cétogène : l’allié caché de votre énergie Le zinc et régime cétogène sont deux alliés puissants pour soutenir vos performances métaboliques et hormonales. Cet oligo-élément joue un …
- Intermittent fasting, keto et compléments : les synergies scientifiquement prouvées L’intermittent fasting, keto et compléments constituent une combinaison de plus en plus étudiée en nutrition …
- La gestion du stress en période de régime est un enjeu central pour la réussite d’une perte de poids durable. De nombreux travaux scientifiques montrent que le stress chronique augmente le cortisol, …
- Enzymes digestives graisses : l’allié scientifique de la diète cétogène La digestion des graisses peut être un véritable défi pour l’organisme, en particulier lors d’un régime cétogène. …
- Vitamine D et régime keto : un duo indispensable La vitamine D et régime keto sont deux éléments souvent associés lorsqu’on s’intéresse à la nutrition, au système immunitaire et à la perte …
- Le régime cétogène, caractérisé par une réduction drastique des glucides au profit des graisses et d’un apport protéique modéré, est devenu une stratégie nutritionnelle prisée chez les sportifs …
- Fibres dans un régime cétogène : solutions efficaces pour éviter la constipation Le régime cétogène, riche en graisses et très pauvre en glucides, a démontré des bénéfices remarquables sur la perte …
- Magnésium cétose bien-être : l’allié indispensable Le magnésium cétose bien-être est devenu une association incontournable dans le cadre d’une alimentation optimisée pour la santé et la performance. …
- Vitamine B9 : un pilier de la santé dans les compléments NUTRILUX DOPA, SERO et HEPATIC La vitamine B9, aussi appelée acide folique, est une vitamine hydrosoluble indispensable à de nombreux …
- Vitamine B8 : un rôle clé dans NUTRILUX VIT&MIN pour le métabolisme et la santé La vitamine B8, plus connue sous le nom de biotine, est une vitamine hydrosoluble essentielle jouant un rôle …
- Vitamine B6 : un cofacteur indispensable dans NUTRILUX DOPA, SERO, VIT&MIN, MAGNESIUM et BASIC La vitamine B6, également connue sous le nom de pyridoxine, joue un rôle fondamental dans plus de …
- Vitamine B5 : coenzyme métabolique clé dans NUTRILUX VIT&MIN et NUTRILUX BASIC La vitamine B5, aussi appelée acide pantothénique, est une vitamine hydrosoluble indispensable au fonctionnement du …
- Vitamine B3 : un coenzyme essentiel dans les produits NUTRILUX Santé La vitamine B3, également appelée niacine ou nicotinamide, est une vitamine hydrosoluble indispensable au …
- Vitamine B2 : un cofacteur métabolique essentiel dans NUTRILUX VIT&MIN La vitamine B2, ou riboflavine, est une vitamine hydrosoluble indispensable au métabolisme énergétique, à la …
- Vitamine B1 : un cofacteur vital dans NUTRILUX VIT&MIN et NUTRILUX BASIC La vitamine B1, également appelée thiamine, est une vitamine hydrosoluble essentielle au bon fonctionnement du métabolisme …
- Manganèse : un oligo-élément indispensable dans NUTRILUX HYALURONIC Le manganèse, oligo-élément vital souvent méconnu, est pourtant indispensable à de nombreuses fonctions biologiques. Présent …
- Protéines végétales vs protéines animales keto : le match décisif Lorsqu’on adopte un régime cétogène, la question des sources de protéines est centrale. Protéines végétales vs protéines animales …
- Sélénium : un oligo-élément essentiel dans NUTRILUX VIT&MIN et NUTRILUX HEPATIC Le sélénium est un oligo-élément indispensable au bon fonctionnement de l’organisme. Présent en quantité …
- Phosphore : un minéral essentiel au cœur de NUTRILUX VIT&MIN Le phosphore, un minéral vital souvent sous-estimé, joue un rôle fondamental dans la physiologie humaine. Présent en quantité …
- Compléments alimentaires régime cétogène : les indispensables Le régime cétogène, ou keto, est un protocole nutritionnel basé sur une consommation élevée de lipides, modérée en protéines et très …
- Compléments pour réguler la glycémie : ce que la science dit Compléments pour réguler la glycémie : un sujet au cœur des enjeux de santé métabolique moderne. Le dérèglement de la glycémie est un …
- Potassium gluconate de potassium : un minéral vital pour l’équilibre cellulaire Le potassium gluconate de potassium est une forme particulièrement biodisponible et bien tolérée de ce …
- Phosphate tricalcique Nutrilux Santé est un composant minéral essentiel présent dans le complément NUTRILUX VIT&MIN. Choisi pour sa haute biodisponibilité et sa parfaite tolérance digestive, il …
- Calcium citrate de calcium et santé : un pilier indispensable Le calcium citrate de calcium est une forme de calcium d’excellente biodisponibilité, fondamentale pour de nombreuses fonctions …
- Gluconate de zinc Nutrilux Santé est au cœur de la formulation de plusieurs compléments alimentaires NUTRILUX Santé, tels que NUTRILUX DOPA, NUTRILUX SERO, NUTRILUX VIT&MIN et NUTRILUX BRONZAGE. …
- Protéines sans sucre et régime cétogène : la synergie parfaite pour maigrir durablement Le recours aux protéines sans sucre régime cétogène est aujourd’hui une stratégie scientifiquement …
- Méthionine Nutrilux Santé : un acide aminé essentiel au métabolisme et à la détoxication La méthionine Nutrilux Santé, présente dans le complément NUTRILUX MAXI LÉGUMES, est un acide aminé …
- Le diabète et la perte de poids sont deux thématiques souvent étroitement liées. De nombreuses personnes atteintes de diabète, notamment de type 2, cherchent à perdre du poids pour mieux contrôler …
- Magnésium NUTRILUX BRAIN : un allié neuroprotecteur à haute biodisponibilité Le magnésium NUTRILUX BRAIN est un complément hautement biodisponible, conçu spécifiquement pour soutenir les fonctions …
- L-Cystine Nutrilux Santé : un acide aminé soufré clé pour les phanères et l’équilibre métabolique La L-Cystine Nutrilux Santé, présente dans le complément NUTRILUX HAIR & NAILS, est un acide …
- Taurine Nutrilux Santé : un acide aminé au service de la neuroprotection et de l’équilibre métabolique La taurine Nutrilux Santé, présente dans les compléments NUTRILUX …
- Tryptophane Nutrilux Santé : un acide aminé au cœur de l’équilibre neuropsychique Le tryptophane Nutrilux Santé, présent dans le complément NUTRILUX SERO, est un acide aminé essentiel indispensable à …
- Tyrosine Nutrilux Santé : un acide aminé essentiel au service de votre bien-être La tyrosine Nutrilux Santé, présente dans les produits NUTRILUX DOPA et NUTRILUX BRONZAGE, est un acide aminé …
- Diabète de type 2 : Comprendre les causes et les symptômes Le diabète de type 2 est une maladie chronique silencieuse et progressive qui touche une part croissante de la population …
- Ashwagandha et bipolarité : une plante adaptogène pour le système nerveux L’ashwagandha et la bipolarité suscitent un intérêt grandissant dans le domaine de la santé naturelle. Utilisée …
- Vitamine D au printemps : un allié essentiel pour votre santé La vitamine D est une vitamine liposoluble essentielle à de nombreuses fonctions physiologiques, notamment la santé osseuse, …
- L-Cystine cheveux : l’acide aminé essentiel pour une chevelure régénérée La L-Cystine est un acide aminé soufré indispensable à la synthèse de la kératine, principale composante des cheveux. …
- Pensée sauvage et détoxification : un atout naturel pour l’organisme La pensée sauvage (Viola tricolor) est une plante aux propriétés médicinales reconnues, notamment pour son action drainante …
- Le Ruscus aculeatus, aussi appelé petit houx, est une plante médicinale reconnue pour ses effets bénéfiques sur la circulation sanguine et le drainage lymphatique. Utilisé depuis l’Antiquité, …
- Resvératrol et santé : un puissant antioxydant aux multiples bienfaits Le resvératrol et la santé sont au centre de nombreuses recherches scientifiques. Ce polyphénol naturel, présent …
- Hamamélys : un allié naturel pour la circulation sanguine et la perte de poids L’Hamamélys circulation sanguine est une plante aux propriétés exceptionnelles, utilisée depuis des siècles pour …
- Ashwagandha et maladie de Parkinson : une approche scientifique L’ashwagandha (Withania somnifera), également connue sous le nom de ginseng indien, est une plante adaptogène utilisée …
- Acide alpha-lipoïque : un antioxydant puissant pour le métabolisme et la concentration L’acide alpha-lipoïque est un antioxydant essentiel impliqué dans le métabolisme énergétique et la …
- Racine de Rhodiola : un allié naturel contre le stress et les pulsions La racine de Rhodiola est reconnue depuis des millénaires pour ses multiples bienfaits sur la santé, en particulier …
- La glutamine : alliée de l’intestin et des performances physiques La glutamine est un acide aminé essentiel conditionnel, largement impliqué dans de nombreux processus biologiques. Connue pour son …
- La passiflore La passiflore (Passiflora incarnata), une plante médicinale aux propriétés apaisantes reconnues, est utilisée depuis des siècles pour ses bienfaits sur le stress et l’endormissement. En …
- Lutter contre la fatigue La fatigue, qu’elle soit passagère ou chronique, touche une grande partie de la population et peut avoir des origines multiples : carences nutritionnelles, stress, sommeil de …
- Ashwagandha et Magnésium : Combo Moral, Fatigue, Stress L’Ashwagandha et le magnésium forment une synergie parfaite pour soutenir le corps et l’esprit, en particulier en période de stress, de fatigue …
- Pectine et digestion La pectine est une fibre alimentaire soluble reconnue pour ses nombreux bienfaits sur la digestion et le transit intestinal. Présente naturellement dans les fruits, elle joue un …
- Lactobacillus gasseri C’est une bactérie probiotique reconnue pour ses multiples bienfaits sur le microbiote intestinal et la santé globale. En tant que composant clé de produits comme NUTRILUX …
- Le safran et ses bienfaits : un trésor en micronutrition Le safran, issu des stigmates séchés de la fleur Crocus sativus L., est utilisé depuis des millénaires pour ses propriétés uniques. …
- Microbiote et probiotiques Le microbiote et les probiotiques sont au cœur de nombreuses discussions sur la santé. Mais que signifient exactement ces termes, et pourquoi leur rôle est-il si crucial en …
- Charbon végétal : propriétés et bienfaits pour la digestion Le charbon végétal est reconnu depuis des siècles pour ses multiples vertus, en particulier sur le système digestif. Ce produit naturel est …
- Anthocyanes et vision : des pigments aux multiples bienfaits Les anthocyanes sont des pigments naturels responsables des teintes rouges, violettes et bleues de nombreux fruits et légumes. …
- Les vitamines : fondements et rôle essentiel pour la santé Les vitamines sont des micronutriments indispensables au bon fonctionnement de l’organisme. Elles interviennent dans de nombreux …
- Feuille de Bacopa : un trésor pour la santé cognitive La feuille de Bacopa, également connue sous le nom de Bacopa monnieri, est une plante adaptogène utilisée depuis des millénaires dans la médecine …
- Bienfaits et usages Le resvératrol est une molécule naturelle aux propriétés antioxydantes puissantes, largement reconnue pour ses effets bénéfiques sur la santé. Présent dans certains …
- Lactobacillus plantarum Lactobacillus plantarum est une bactérie probiotique essentielle, reconnue pour ses nombreux bienfaits sur la santé digestive, immunitaire et hormonale. Présent dans …
- Code promo gourde ÖKO : l’intérêt de boire une eau pure et saine Code promo gourde ÖKO : Bénéficiez de 10 % de réduction avec le code OKONUTRILUX. Boire de l’eau de qualité est une nécessité …
- Le gatillier : bienfaits et utilisations pour les femmes Le gatillier (Vitex agnus-castus), aussi appelé « arbre au poivre », est une plante reconnue depuis l’Antiquité pour ses bienfaits …
- Lactobacillus acidophilus Lactobacillus acidophilus, l’une des souches probiotiques les plus étudiées, joue un rôle central dans la santé humaine. Ce micro-organisme bénéfique, présent naturellement …
- Thym Thymus vulgaris : un allié naturel pour votre santé Le thym, ou Thymus vulgaris, est une plante médicinale réputée pour ses nombreuses propriétés bénéfiques sur la santé. Utilisé depuis …
- Les bienfaits de l’extrait de feuille de Bacopa IntroductionL’extrait de feuille de Bacopa, reconnu pour ses propriétés neuroprotectrices, est utilisé depuis des siècles en médecine ayurvédique pour …
- Graine de carvi : bienfaits et utilisation La graine de carvi, issues de Carum carvi, sont des alliées reconnues pour leurs multiples bienfaits sur la digestion et le bien-être intestinal. Utilisées …
- L’ashwagandha, aussi appelée ginseng indien, est une plante issue de la pharmacopée traditionnelle ayurvédique. Utilisée depuis plus de 3 000 ans en Inde, elle commence tout juste à se faire …
- Criste marine : alliée naturelle pour le drainage et la perte de poids La criste marine, également connue sous le nom de fenouil marin, est une plante aux multiples bienfaits pour la santé. Utilisée …
- Les bienfaits du fruit du Tribulus pour la santé et la fertilité Le fruit du Tribulus terrestris, une plante largement utilisée en phytothérapie, est reconnu pour ses nombreux bienfaits sur la santé …
- Bifidobacterium bifidum : Un allié essentiel pour la santé intestinale et globale Le Bifidobacterium bifidum, l’une des souches probiotiques les plus étudiées, joue un rôle clé dans l’équilibre …
- La glucosamine : un allié pour vos articulations et votre bien-être La glucosamine est un composant clé pour le maintien de la santé des articulations et des tissus conjonctifs. Naturellement …
- La dopamine et la tyrosine : des alliés pour votre bien-être avec NUTRILUX Santé Introduction La dopamine et la tyrosine jouent un rôle crucial dans notre santé mentale et physique. La dopamine, …
- Vitamine C : un indispensable pour la santé Introduction Vitamine C, aussi appelée acide ascorbique, est essentielle pour le bon fonctionnement de l’organisme. Antioxydante, immunostimulante et …
- Extrait d’écorce de Prunier d’Afrique : un allié pour la prostate Introduction Extrait d’écorce de Prunier d’Afrique : ce complément naturel est reconnu pour ses bienfaits sur la santé de la …
- Mélatonine : Bienfaits pour le Sommeil, la Perte de Poids et l’Anti-âge La mélatonine est souvent associée à la régulation du sommeil, mais ses bienfaits vont bien au-delà. En effet, des études …
- Les Bienfaits du Magnésium pour un Équilibre Mental et Physique Le magnésium est un minéral essentiel pour de nombreuses fonctions corporelles, jouant un rôle clé dans le maintien de l’équilibre …
- Diabète et Chrome : Effets et Bénéfices des Produits Nutrilux Santé Le diabète, un trouble métabolique chronique caractérisé par un taux de glucose sanguin trop élevé, est devenu un enjeu majeur de …
- Burn out : vitamine D et Ashwagandha, le combo magique de NUTRILUX Santé Introduction Le burn-out est une réalité de plus en plus fréquente dans notre société moderne. Ce syndrome d’épuisement …
- Picolinate de chrome et diabète: les bienfaits pour la santé Définition du Diabète : Symptômes, Types et Évolution Le diabète est une maladie chronique caractérisée par un excès de glucose dans le …
- De plus en plus, on se demande s’il est raisonnable de maigrir en utilisant les compléments alimentaires. Assurément, il convient de mesurer les avantages et les dangers avant de s’y lancer. Maigrir …